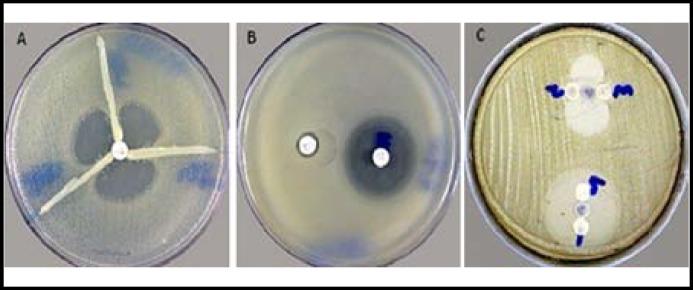
https://cdn.ncbi.nlm.nih.gov/pmc/blobs/7d62/3858913/2892779d0a29/pjms-29-1253-g002.jpg

巴基斯坦伊斯兰堡三级护理医院临床样本中多重耐药鲍曼不动杆菌的流行情况。
Prevalence of multi drug resistant Acinetobacter baumannii in the clinical samples from Tertiary Care Hospital in Islamabad, Pakistan.
机构信息
Shahzeera Begum, Department of Microbiology, Faculty of Biological Sciences, Quaid-i-Azam University, Islamabad, Pakistan.
Fariha Hasan, Department of Microbiology, Faculty of Biological Sciences, Quaid-i-Azam University, Islamabad, Pakistan.
出版信息
Pak J Med Sci. 2013 Sep;29(5):1253-8. doi: 10.12669/pjms.295.3695.
BACKGROUND & OBJECTIVES: Acinetobacter baumannii can cause a wide range of infections, including bacteremia, pneumonia, urinary tract infection, peritonitis, etc. This organism is becoming resistant to a large group of antibiotics, especially β-lactam antibiotics. The reason for multi-drug resistance may be the production of extended- spectrum β-lactamses (ESBLs), carbapenemases/metallo β-lactamases or AmpC β-lactamases. The aim of the present study was to determine the prevalence of multi-drug resistant Acinetobacter baumannii isolated from the patients in Surgical Intensive Care Units (SICUs) of Pakistan Institute of Medical Sciences (PIMS), Islamabad, Pakistan.
METHODS
A total of 91 A. baumanni isolates were collected from PIMS during the period from February 2011 to December 2011. The antibiotic susceptibility testing was performed by standard disc diffusion method as recommended by CLSI. Combination disc method, Modified Hodge test, EDTA disc synergy test and AmpC disc test were performed for detection of ESBLs, carbapenemases, metallo β-lactamases, and AmpC β-lactamases, respectively.
RESULTS
The prevalence of MDRs was reported 100% among A. baumannii. The antibiotic susceptibility profile showed that minocycline and tigecycline were the most effective drugs against A. baumannii. Almost all of A. baumannii isolates were carbapenemase and metallo β-lactamase producers. AmpC prevalence was observed in 41.76%, while none of the isolates was ESBL producer. Antibiogram and minimal inhibitory concentrations (MICs) indicated tetracycline is relatively effective against A. baumanii.
CONCLUSIONS
Increased frequency of multi-drug resistance supports the need for continuous surveillance to determine prevalence and evolution of these enzymes in Pakistan.
背景与目的
鲍曼不动杆菌可引起广泛的感染,包括菌血症、肺炎、尿路感染、腹膜炎等。该菌对一大类抗生素,特别是β-内酰胺类抗生素耐药。多药耐药的原因可能是产生了超广谱β-内酰胺酶(ESBLs)、碳青霉烯酶/金属β-内酰胺酶或AmpC β-内酰胺酶。本研究旨在确定巴基斯坦伊斯兰堡巴基斯坦医学科学院(PIMS)外科重症监护病房(SICUs)分离的多药耐药鲍曼不动杆菌的流行率。
方法
2011 年 2 月至 2011 年 12 月期间,从 PIMS 共收集了 91 株鲍曼不动杆菌。药敏试验采用 CLSI 推荐的标准纸片扩散法进行。采用联合纸片法、改良 Hodge 试验、EDTA 纸片协同试验和 AmpC 纸片试验分别检测 ESBLs、碳青霉烯酶、金属β-内酰胺酶和 AmpC β-内酰胺酶。
结果
鲍曼不动杆菌的 MDRs 流行率为 100%。药敏谱显示米诺环素和替加环素对鲍曼不动杆菌最有效。几乎所有的鲍曼不动杆菌分离株均为碳青霉烯酶和金属β-内酰胺酶的产生者。AmpC 的检出率为 41.76%,而无 ESBL 产生者。药敏试验和最小抑菌浓度(MICs)表明四环素对鲍曼不动杆菌相对有效。
结论
多药耐药率的增加支持需要进行持续监测,以确定这些酶在巴基斯坦的流行率和演变。